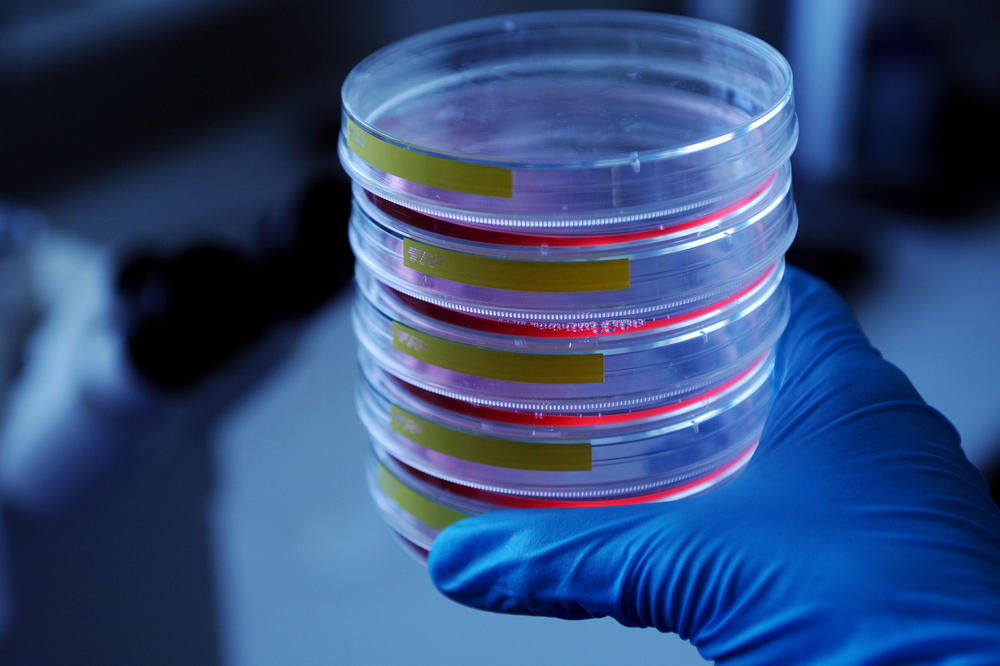
Exportkontrollrechtlich relevant? Das muss bei Forschung, die dual genutzt werden kann, geprüft werden.

Was hat Wissenschaft mit Exportkontrolle zu tun?
Informationsveranstaltung am 11. Mai, 9.30 bis 16.30 Uhr, im Max-Kade-Auditorium im Henry-Ford-Bau / Kooperation mit dem BAFA, dem Auswärtigen Amt und dem BMWK
22.04.2022
Exportkontrollrechtlich relevant? Das muss bei Forschung, die dual genutzt werden kann, geprüft werden.
Bildquelle: David Ausserhofer
Was hat eine Universität mit Außenhandel zu tun? Die Antwort: mehr, als man zunächst denken mag. Schließlich wird in der Wissenschaft produziert und ausgetauscht: Wissen, Forschungsergebnisse, Produkte. Forschende tauschen Materialien, Technologien, wissenschaftliche Gerätschaften international untereinander aus, arbeiten zusammen in Laboren und Verbünden, nutzen gemeinsam Software und Daten. Das geschieht zum Nutzen der Wissenschaft und im Sinne der Wissenschaftsfreiheit. Doch wo sind die Grenzen? Wie kann die Freiheit der Wissenschaft gewahrt werden? Wer trägt die Verantwortung, wenn Forschung missbraucht oder manipuliert wird?
Unter dem Titel „Exportkontrolle & Academia“ findet am 11. Mai von 9.30 bis 16.30 Uhr im Audimax der Freien Universität Berlin eine große Informationsveranstaltung statt. Partner sind das Bundesamt für Wirtschaft und Ausfuhrkontrolle (BAFA), das Auswärtige Amt sowie das Bundesministerium für Wirtschaft und Klimaschutz. Eingeladen sind Lehrende, Forschende und Mitarbeitende aus der Verwaltung von Freier Universität Berlin, Humboldt-Universität zu Berlin, Technischer Universität Berlin, Charité – Universitätsmedizin Berlin und der Universität Potsdam.Professor Benedikt Kaufer, Virologe am Fachbereich Veterinärmedizin der Freien Universität Berlin, ist stellvertretender Vorsitzender der „Kommission für Ethik sicherheitsrelevanter Forschung“, kurz KEF, die derzeit gemeinschaftlich von Charité – Universitätsmedizin Berlin und Freier Universität Berlin gegründet wird. Der Veterinärmediziner und der promovierte Jurist Andreas Schoberth, Leiter des Rechtsamts der Freien Universität, erläutern, welche Dimensionen das Thema Exportkontrolle für die Freie Universität Berlin hat.
Herr Professor Kaufer, Herr Schoberth, worum wird es bei der Informationsveranstaltung „Exportkontrolle & Academia“ am 11. Mai gehen?
Andreas Schoberth: Die Veranstaltung soll ein Auftakt sein und alle an der Universität Beschäftigten für das Themenfeld Exportkontrolle sensibilisieren. Die meisten Universitätsangehörigen werden sich bisher nicht mit Außenhandel und Exportkontrolle beschäftigt haben.
Dr. Andreas Schoberth, Leiter des Rechtsamts der Freien Universität Berlin
Bildquelle: Bernd Wannenmacher
Das führt zu der Frage, was die Freie Universität und ihre Beschäftigten mit den Themen Außenwirtschaft und Exportkontrolle zu tun haben?
Schoberth: Die Freie Universität Berlin ist eine internationale Netzwerkuniversität und pflegt Kontakte in alle Welt. Wenn beispielsweise Virenstämme, die am Fachbereich Veterinärmedizin entwickelt wurden, ins Ausland verschickt werden, nimmt die Universität am Außenhandel teil.
Oder: Wir begrüßen auf unserem Campus Forschende und Lehrende aus aller Welt, die Zugang zu unseren Laboren, zu Wissen haben. Wenn die dort betriebene Forschung sicherheitsrelevant ist, kann das unter das Regime der Exportkontrolle fallen.
Auch wenn Forschungsergebnisse nur dual genutzt werden können, das heißt, sowohl zivil, aber auch zumindest potenziell militärisch, aggressiv, wie bestimmte Chemikalien, Maschinen, Technologien und Werkstoffe, aber insbesondere auch Software, kann das exportkontrollrechtlich relevant sein.
Prof. Dr. Benedikt Kaufer, Virologe am Fachbereich Veterinärmedizin der Freien Universität Berlin.
Bildquelle: Kia Malik
Benedikt Kaufer: Das ist die eine Seite. Ihr gegenüber steht die Wissenschaftsfreiheit: Denn um als Menschheit voranzukommen, müssen Forschende ihr Wissen teilen. Wenn keine Kommunikation stattfindet, geht Forschungsleistung verloren. Wissen zu teilen, ist ein ganz wichtiger Aspekt.
Schoberth: Es geht um einen guten Austausch zwischen Wissenschaft und Recht. Exportkontrolle soll Forschung nicht verhindern. Es gilt aber sicherzustellen, dass sich Forschung innerhalb der Rechtsordnung bewegt und nicht durch Dritte für unfriedliche Zwecke missbraucht werden kann. Mit diesem Spannungsfeld beschäftigt sich auch die „Kommission für Ethik sicherheitsrelevanter Forschung“, der Herr Kaufer mitvorsitzt.
Was genau ist Aufgabe der KEF?
Kaufer: Die KEF besteht aus 12 Mitgliedern aus verschiedenen Disziplinen und Einrichtungen, Vorsitzende ist Professorin Susanne Michl von der Charité. Wir stehen Forschenden beratend zur Seite und können prüfen, was in der Forschung unterhalb der juristischen Ebene ethisch vertretbar ist. Und wir beraten. Denn juristische Fachleute können nicht in jedem Fall beurteilen, ob ein Forschungsgegenstand in einem bestimmten Fach sicherheitsrelevant ist oder nicht. Grundsätzlich gilt: Alles, was bereits veröffentlicht ist, fällt nicht mehr unter die Exportkontrolle. Dasselbe gilt für Grundlagenforschung. In diesen Bereichen geht es dann aber um eine wissenschaftsethische Dimension: Hätte beispielsweise der Quellcode des aggressiv einsetzbaren Softwaretools allgemein zugänglich gemacht werden dürfen? Gerade damit soll sich die KEF auch befassen.
Gibt es Fächer an der Freien Universität, die besonders mit Exportkontrolle zu tun haben könnten?
Schoberth: Die Veterinärmedizin wurde schon genannt, Ähnliches gilt für den Fachbereich Biologie, Chemie, Pharmazie. Dann Mathematik und Informatik: KI-Tools können dual verwendet werden: als Software für die Gesichtserkennung – oder für die Bestückung bewaffneter Drohnen, die bestimmte Menschen erkennen sollen. Oder nehmen wir den Fachbereich Geowissenschaften: Wenn dort entwickelte Geräte an die NASA geliefert werden, die auf den Mond geschickt werden, ist das exportrechtlich relevant. Noch ein Beispiel: Laser, die am Fachbereich Physik entwickelt und verschickt werden.
Welche weiteren Einrichtungen oder Personen an der Freien Universität müssen sich mit dem Thema Exportkontrolle beschäftigen?
Schoberth: Die Personalabteilung bei der Einstellung von Beschäftigten und bei der Genehmigung von Dienstreisen ins Ausland, wenn es darum geht, wer mit welcher Technologie in welche Länder reist. Die Poststelle, wenn es um den Versand von Geräten an Forschungspartner im Ausland geht. Der Zentrale Einkauf, wenn es um den Einkauf wissenschaftlicher Güter aus dem Ausland geht und dabei Geldflüsse an potenziell exportkontrollrechtlich bedenkliche Unternehmen etwa aus Iran, Sudan, Kuba, Russland, China oder Nordkorea abgehen. Die Abteilungen Internationales und Forschung in Hinblick auf Gastwissenschaftlerinnen und -wissenschaftler auf unserem Campus.
Wer an der Freien Universität ist für die Einhaltung der Regelungen zur Außenwirtschaft verantwortlich?
Schoberth: Organisationsverantwortlich ist die Kanzlerin. Unterstützt wird sie dabei vom Rechtsamt. Das Thema ist aber ein Querschnittsthema und zieht sich durch die ganze Universität – Forschende ebenso wie Beschäftigte in der Verwaltung können betroffen sein. Deshalb ist es auch so wichtig, dass sich alle informieren. Denkbar ist, dass mittelfristig an den Fachbereichen und administrativen Einrichtungen jeweils Ansprechpersonen benannt werden, die bei Fragen kontaktiert werden können.
Kann Fehlverhalten sanktioniert werden?
Schoberth: Ja, Verstöße gegen die Exportkontrolle sind strafbewehrt: Sie können mit einer Geld- oder Freiheitsstrafe geahndet werden. Schlimmer aber bei einem Verstoß ist meist die Rufschädigung für die Einrichtung.
Wie sehr haben Wissenschaftseinrichtungen in Deutschland das Thema Exportkontrolle und ethisch-sicherheitsrelevante Forschung im Blick?
Kaufer: Das Thema KEF wurde von der Nationalen Akademie der Wissenschaften Leopoldina angestoßen. Es gibt schon viele Universitäten, die solche Kommissionen gegründet haben. Unter den Berliner Universitäten wird die gemeinschaftliche KEF von Charité und Freier Universität Berlin aber die erste dieser Art sein.
Schoberth: Mit dem Thema Exportkontrolle in seiner ganzen Breite befassen sich die außeruniversitären Einrichtungen, etwa die Max-Planck-Institute, schon länger. Auch die technischen Universitäten nehmen das Thema schon seit einiger Zeit sehr ernst: So hat etwa die RWTH Aachen inzwischen ein mehrköpfiges Team aufgebaut, das sich mit dem Thema Exportkontrolle beschäftigt. An den Volluniversitäten hat das erst in den vergangenen Jahren langsam angefangen. Es ist deshalb wichtig und richtig, dass die Freie Universität mit der Informationsveranstaltung am 11. Mai Beschäftigte der Universitäten in Berlin und Potsdam für das Thema sensibilisiert.
Die Fragen stellte Christine Boldt
Weitere Informationen
Anmeldung bitte möglichst bis 27. April 2022 per Mail an rechtsamt@fu-berlin.de Bitte teilen Sie dabei unbedingt mit, ob Sie in Präsenz oder online teilnehmen.
- 11. Mai 2022 | 09:30 bis 16:30
- Freie Universität Berlin, Henry-Ford-Bau, Max-Kade-Auditorium (Garystraße 35, 14195 Berlin) sowie online
Das detaillierte Programm ist hier abrufbar.